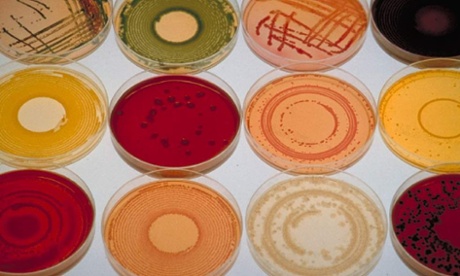
Various bacterial cultures in petri dishes

We don’t expect year 7s to be as skilled as sixth formers, so why do we expect newly qualified teachers to be as proficient as those who have been in the profession for a decade?
If you have a quick scan through the cover list at my school you will note a repeating pattern: the newly qualified teachers (NQTs) are ill. They’re ill a lot. We old warhorses have come into contact with every germ, virus and bacteria that the biological soup that is our student body can propagate, and our immune systems are made of stern stuff.
The poor NQTs are still developing this immunity and so we’d expect them to be off a bit more – rather like babies when they first get to nursery. However, some of them are off because of stress and we could inoculate them against this far more effectively than we do.
When I joined the profession there were different teaching standards for NQTs. My school recognised that I didn’t have a back catalogue of copious resources: everything I taught had to be planned from scratch. On top of that I had to learn a lot, very quickly.
There were topics I was rusty on and others that I knew nothing about. For most of that year I was about three pages ahead of my students in the textbook, frantically cramming knowledge for all I was worth. At the same time, I turned out workmanlike lessons. There was even some group work sometimes (when I was being observed, usually), but the lessons weren’t going to set education on fire. And actually, that was fine: I was a metaphorical year 7 and I was laying the groundwork to improve and develop.
If I dig my NQT file out there were some “goods” but there were also a whole load of “satisfactories” because I was lucky enough to learn to teach when educational weasel words hadn’t transformed the latter into “requires improvement”. My mentor judged those satisfactory lessons using standards that were less onerous than those expected of fully qualified colleagues. My satisfactory as an NQT was not the equivalent of a satisfactory for a fully qualified teacher.
This system recognised that I was developing, learning and acquiring skills that experienced colleagues already had. There is little point in marking a year 7 assessment using an A-level marking scheme – all you will identify is that it takes most students seven years to be good enough to be judged by those standards. However, in education today NQTs are judged according to general teaching standards and, more often than not, they are found wanting.
These young NQTs (usually) arrive fired up with enthusiasm and verve and we grind it out of them really quickly. They are expected to know the intricacies of ever-changing exam syllabi immediately. Marking has to be incredibly detailed and personalised. Data needs to be easily recalled and analysed in depth, with intervention planned according to specific needs. Lessons need to be outstanding or good, judged according to the skillset of colleagues who have done this for decades.
Colleagues who know all the students, their siblings, and their parents have the advantage of that familiarity when it comes to classroom management. They have done many hours of CPD (continuing professional development) over many years. They have learned and taught every topic many times, and observed many lessons on those subjects delivered by other experienced practitioners. These colleagues made clanging teaching mistakes in the privacy of their own classrooms in the days before anyone had heard of a walk-through.
So, NQTs inevitably “require improvement”. Well, actually, we all do. But those of us who have been in the profession longer have enough experience to usually avoid that grading when observed. Support plans are activated and meetings held with concerned mentors. We tell young teachers that they’re just not good enough and we’ve all seen the fallout: the tears in the staffroom, the thousand-yard stare in the corridor, the slumped shoulders at the desk at the end of another harrowing lesson with year 9, the resignation letter in the second year of teaching.
The worst part of this is that we are teachers and we understand learning; or we should do. We know that learning is incremental, based on trial and (more valuably) error, takes years, and involves a huge amount of different stimuli.
Our year 7s write about Shakespeare in a different way to our year 9s; the painting of a year 10 is less proficient than that same student in year 13. So why does my profession ignore this when it comes to NQTs? Why do we drive them out by saying they’re not good enough right now, when we can see that one day they will be just as proficient as the most experienced among us? What they need is time, assistance, a bit of latitude, kindness, understanding – and maybe some anti-bacterial hand wash.








